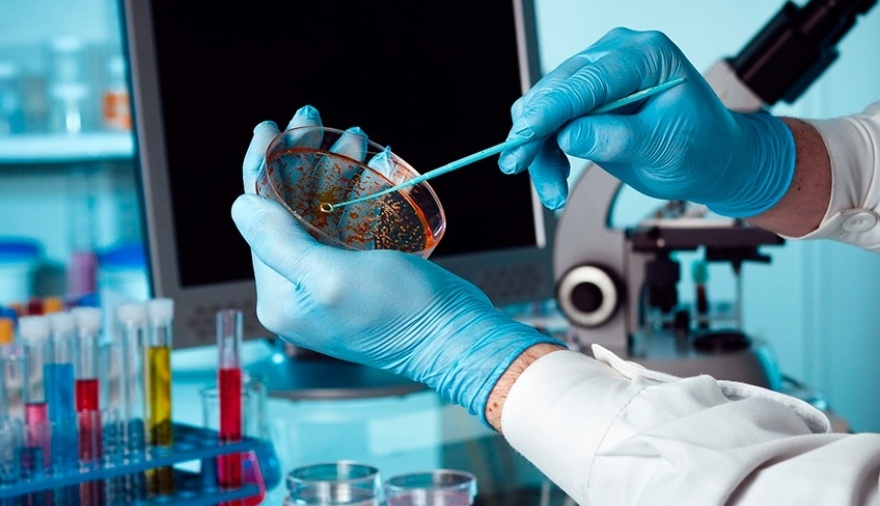

Sociedad
Coronavirus
Moderna realizará pruebas para determinar si la vacuna protege contra nueva cepa del coronavirus
22/12/2020 | La empresa Moderna informó hoy que realizará pruebas adicionales para determinar si la vacuna elaborada para enfrentar el coronavirus protege contra la nueva versión mutada del virus hallado en el Reino Unido.
por Redacción
Moderna precisó que según los datos hasta la fecha, aguardan que "la inmunidad inducida por la vacuna proteja contra las variantes descritas recientemente en el Reino Unido".
"Realizaremos pruebas adicionales en las próximas semanas para confirmar esta expectativa", precisó Moderna en un comunicado.
Pfizer y Moderna fabrican las únicas dos vacunas contra el coronavirus que fueron autorizadas por la Administración de Alimentos y Medicamentos (FDA por si sigla en inglés) de los Estados Unidos y ahora probarán si funcionan contra la nueva versión mutada del virus hallada en Reino Unido y otros países.
El nuevo coronavirus ha mutado antes, y ambas compañías dicen que descubrieron que sus vacunas funcionaron contra otras variaciones del virus.
En tanto, el laboratorio alemán BioNTech, que junto al estadounidense Pfizer produjo la primera vacuna aprobada internacionalmente contra el coronavirus, prevé suministrar "en seis semanas" una vacuna adaptada a la nueva cepa del virus que se registró en el Reino Unido.
Algunos investigadores que están examinando el genoma de la variante del Reino Unido señalaron que les preocupa que las mutaciones de esta variante posiblemente disminuyan un poco la efectividad de la vacuna, consignó la CNN.
"Se podría imaginar un impacto modesto en la eficacia de la vacuna, lo cual no sería bueno, pero no creo que rompa la vacuna", dijo Trevor Bedford, profesor asociado de la división de vacunas y enfermedades infecciosas del Centro de Investigación Fred Hutchinson Cancer.













